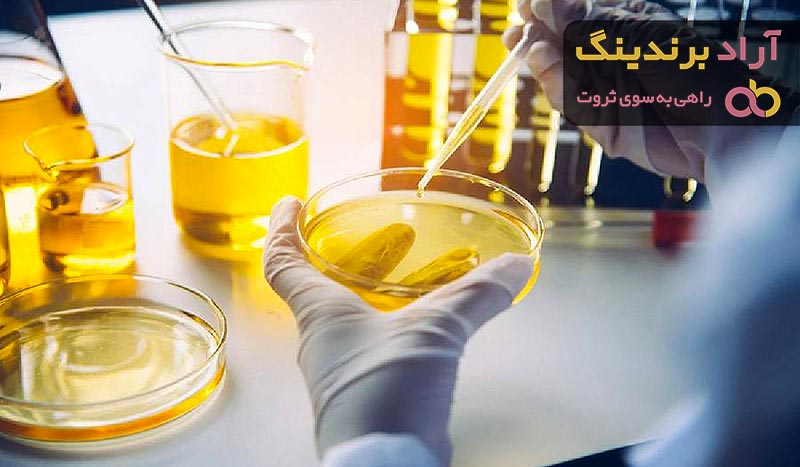
بهترین روغن های پایه سنتتیک + قیمت خرید عالی

در این مقاله نمونه های متنوع و کاربردی از انواع روغن پایه گروه 3 و همچنین سنتتیک را معرفی می نماییم که دارای مشتقات خاص خود بوده و دسته بندیهای متفاوتی را دارا می باشند.
شایان ذکر است که در فرآیند تولید روغن پایه گروه 3،یا روغن پایه sn350 هیدروژنه شدن طی حرارت بالایی صورت می گیرد و از طرفی تحت فشار بسیار شدیدی نیز تهیه می شود.
یکی از مزیتهای فرآیند تولید روغن پایه گروه 3 و روغن پارافینیک این است که مواد ناخالص یا غیر مطلوب دارای قابلیت مفیدی شده و تماماً تبدیل به ترکیبات کربنی می شوند.
از عمده خواص روغن پایه گروه 3 این است که به میزان بسیار اندکی در آن از مواد ناخالص بهره گرفته شده است و در نتیجه این عامل موجب شده است تا کارکرد و ماندگاری موتور به بهترین شکل ممکن حفظ شود.
روغن پایه گروه 3 تحت فرآیند کاتالیستی قرار می گیرند و در واقع فشار بالایی را برای آن اعمال نموده تا این امکان فراهم آید بهترین نوع روغن پایه تولید شود.
لازم به ذکر است که طی فرآیند تهیه روغن پایه گروه 3 موادی حاصل می آیند که بسیار زلال بوده و این مزیت را نیز دارا بوده تا در برابر سایش نیز مقاومت مناسبی را داشته باشند.
دیگر محصولاتی که می توانند کاربرد فراوانی داشته باشند، روغن پایه سنتتیک است که می تواند در برابر اکسیداسیون مقاوم عمل نموده و همچنین قادر می باشد در برابر حرارتهای بالای 400 درجه نیز مقاومت نمایند.

انواع روغن پایه گروه 3
در این قسمت به ذکر بهترین نمونه های موجود در بازار می پردازیم که می توانند کارایی عالی را برای موتور داشته باشند که ما در این مطلب انواع روغن پایه گروه 3 را برای این امر مورد بررسی قرار می دهیم. در این قسمت نمونه های منحصر به فردی از روغن پایه گروه 3 را معرفی می نماییم که شامل موارد ذیل می باشند:
- روغن پایه معدنی
- روغن پایه سنتزی
- روغن پایه نچرال
ابتدا نوع منحصر به فرد روغن پایه گروه 3 را مورد بررسی قرار می دهیم و بازگو می شویم که این نوع محصول به منظور استفاده در وسایل نقلیه سنگین همچون کامیون کشنده در نظر گرفته شده است و در فرآیند تولید آن، هیدروکربنها نقش بسزایی را دارا می باشند.
لازم به ذکر است که در طی تولید روغن پایه سنتزی به میزان بسیاری هیدروکربنهای حلقوی وجود دارد که موجب می شود تا این ماده از اکسیداسیون برخوردار نشود.
نوع دیگری از روغن پایه گروه 3 را تهیه نموده ایم که نام سنتزی را به خود اختصاص نموده است و همواره در طی تولید آن نفت را مورد پالایش قرار داده تا این نوع ماده یکی از بهترین و کاربردی ترین محصولات بین سایر روغنها باشد.

و سرانجام روغنهای پایه گیاهی که تمام متریال آنها از گیاهان برگرفته شده است و می توانند به عنوان یک ماده بی نظیری و دوستدار محیط زیست شناخته شوند. تمام این مواردی را که در این دسته بندی ذکر نموده ایم، همچون روغن موتور می توانند از ناخالصی کمتر برخوردار بوده و در نتیجه میزان کارایی موتور را ارتقا بخشند.
دیگر مزیتی را که می توانیم برای روغن پایه 3 در نظر بگیریم، میزان استقامت و تحمل آن در برابر دماهای بالا بوده که در واقع نشان دهنده کارایی بهتر آن برای محافظت از موتور می باشد.
این روغنهای پایه گروه 3 می توانند تمام قسمتهای موتور به همراه متعلقات آن را مورد روانکاوی قرار داده و در نتیجه این قابلیت فراهم آید تا نحوه کارکرد موثرتری را به همراه بیاورد.
شایان ذکر است که روغنهای پایه گروه 3 می توانند از ایجاد رسوب و املاح مضر نیز ممانعت به عمل بیاورند و در نتیجه تمامی موادهای غیر ضروری که کارکرد موتور را مختل نموده را برطرف نمایند.

روغن پایه سنتتیک
در انتهای این مقاله نمونه کاربردی و مناسبی را معرفی می نماییم که روغن پایه سنتتیک بوده و می تواند در برابر باکتریها نیز مقاوم بوده و این زمینه فراهم می آید تا از دوام بالاتری برخوردار باشد.
یکی از مزیتهای ویژه روغن پایه سنتتیک این است که می تواند در آبهای بسیار سخت نیز مقاومت نموده و به آسانی حل شود و لازم به ذکر است که محصولات مذکور میزان خنکی قابل توجهی را به موتورها می بخشد تا شاهد کارکرد بهتر در برابر حرارت بالا باشیم.
روغن پایه سنتتیک و روغن هیدرولیک ویژگیهای منحصر به فرد دیگری را نیز دارا می باشد که به عنوان یک ماده کاربردی می توانیم به تاثیر بالای آن در دوام و مدت ماندگاری موتورها اشاره نماییم که در واقع این زمینه حاصل می شود تا پس از طی نمودن مسیرهای طولانی نیز احتیاج به تعویض آن نباشد.
یک فایده ویژه ای برای روغن پایه سنتتیک وجود دارد که می توان به عدم وجود املاح سمی اشاره نمود که این عامل موجب می شود تا موتورهای وسایل نقلیه به بهترین شکل ممکن کار نموده و همواره سایش و اصطکاک به حداقل برسد.

در واقع این روغن پایه سنتتیک دارای املاح بسیار کاربردی است که وارد مسیرهای مختلف موتور شده و می تواند با دارا بودن مواد کاملاً روانکاو میزان استفاده از سوخت را نیز کاهش داده و در نتیجه استقبال بالایی برای این محصول را شاهد باشید.
شایان ذکر است که روغن پایه سنتتیک غلظت قابل قبولی را داشته و می تواند مانع از کاویتاسیون شود و همچنین پمپهای روغن را از آسیب دور می نماید.
بسیاری از افراد بر این باور می باشند که روغن موتور یا روغن وکیوم لازم است به سرعت دودی شده تا نشان از کارکرد موثر آن باشد که ما لازم می دانیم بازگو نماییم که این روغنهای مذکور از قابلیتی برخوردار می باشند که سیاه شدن آنها به طور تدریجی صورت پذیرفته و در نتیجه این امر نشان دهنده مرغوب بودن روغن پایه سنتتیک می باشد.
ما تمام مزیتهای روغنهای پایه گروه 3 و همچنین سنتتیک را بیان نموده ایم تا شما این نکته را در نظر بگیرید که برای روانکاوی نمودن موتور خودروها و سایر تجهیزات مکانیکی به کار برده می شود.
لازم است عواملی را که در تعیین قیمت روغنهای پایه گروه 3 و سنتتیک مورد توجه قرار می گیرند را بیان نماییم تا شما نسبت به نرخ آنها اطمینان خاطر یابید.
این نوع محصولات دارای مواد اولیه گوگرد با گرانروی بالا، نفت پالایش شده، آلکانها، اسیدهای کافی و غیره می باشند و با توجه به اینکه تعدد این متریال را شاهد می باشیم، می توانیم بگوییم که قیمتهای مقرون به صرفه ای را می توان برای آنها در نظر گرفت.
ما این زمینه را ایجاد نموده ایم تا شما متقاضیان گرامی به این وبگاه مراجعه نمایید و تمام روغنهای پایه گروه 3 و سنتتیک را مشاهده نموده و سپس با دریافت راهنمایی از کارشناسان این مجموعه اقسام متفاوت و منحصر به فردی را خریداری نمایید.